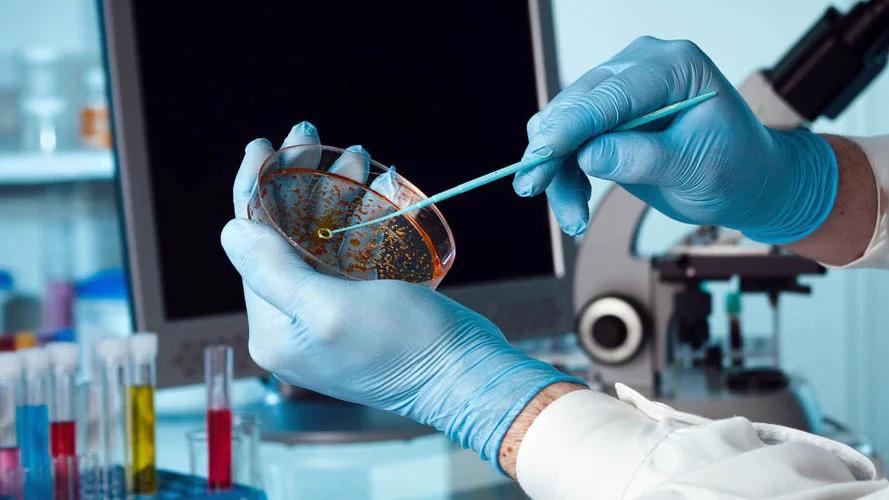
Επανάσταση στην ανίχνευση του καρκίνου

Επανάσταση στην ανίχνευση του καρκίνου
Το κλειδί αυτής της πρωτοποριακής μεθόδου βρίσκεται σε μικροσκοπικά θραύσματα γενετικού υλικού (DNA) που αποβάλλονται από τους όγκους και κυκλοφορούν στην κυκλοφορία του αίματος. Αυτά τα ελεύθερα κυκλοφορούντα όγκου DNA (ctDNA) φέρουν «υπογραφές» –μοναδικές γενετικές αλλαγές– που προδίδουν την παρουσία καρκινικών κυττάρων στο σώμα, ακόμα και σε πολύ πρώιμα στάδια.
Εάν μια κατάλληλη και ευαίσθητη μέθοδος ανάλυσης, ικανή να ανιχνεύει αυτές τις υπογραφές του DNA στο αίμα, αναπτυχθεί σε μεγάλη κλίμακα, αυτό θα σήμαινε την αυτόματη δημιουργία ενός αξιόπιστου και μη επεμβατικού τρόπου για την ανίχνευση του καρκίνου πολύ νωρίτερα από τις υπάρχουσες μεθόδους. Αυτό θα μπορούσε να μεταμορφώσει την προληπτική ιατρική και να δώσει ένα ισχυρό όπλο στα χέρια των κλινικών ιατρών.
Τα πρώταενθαρρυντικά αποτελέσματα
Η ερευνητική ομάδα, στο πλαίσιο μιας ευρύτερης μελέτης, ανέλυσε δείγματα αίματος από 26 άτομα που διαγνώστηκαν με καρκίνο εντός έξι μηνών από τη συλλογή του δείγματος. Αυτά τα δείγματα συγκρίθηκαν με δείγματα αίματος από άτομα που δεν είχαν εμφανίσει καρκίνο.
Το τεστ έγκαιρης ανίχνευσης πολλαπλών μορφών καρκίνου (MCED), που ανέπτυξαν οι ερευνητές, κατάφερε να ανιχνεύσει καρκίνο σε οκτώ από τους 52 συμμετέχοντες στη μελέτη. Συνολικά, το 31% των ατόμων που εμφάνισαν καρκίνο εντοπίστηκαν από την ανάλυση του αίματος. Αν και η ορολογία της έρευνας περιλαμβάνει εξειδικευμένους ιατρικούς όρους, τα αρχικά αυτά αποτελέσματα είναι εξαιρετικά ενθαρρυντικά και ανοίγουν τον δρόμο για περαιτέρω κλινικές δοκιμές σε μεγαλύτερο πληθυσμό.
Γιατί είναι σημαντική η έγκαιρη διάγνωση;
Η έγκαιρη διάγνωση του καρκίνου είναι ζωτικής σημασίας για πολλούς λόγους:
- Αυξημένα ποσοστά ίασης: Όταν ο καρκίνος εντοπίζεται σε αρχικά στάδια, πριν εξαπλωθεί σε άλλα όργανα, οι πιθανότητες πλήρους ίασης είναι σημαντικά υψηλότερες.
- Λιγότερο επεμβατικές θεραπείες: Η έγκαιρη ανίχνευση συχνά επιτρέπει τη χρήση λιγότερο επιθετικών θεραπειών (π.χ., μικρότερες χειρουργικές επεμβάσεις, λιγότερη χημειοθεραπεία ή ακτινοβολία), μειώνοντας τις παρενέργειες και βελτιώνοντας την ποιότητα ζωής του ασθενούς.
- Πρόληψη μεταστάσεων: Ο κύριος κίνδυνος του καρκίνου είναι η μετάσταση, δηλαδή η εξάπλωση των καρκινικών κυττάρων σε άλλα μέρη του σώματος. Η έγκαιρη διάγνωση μπορεί να αποτρέψει ή να καθυστερήσει αυτή τη διαδικασία.
- Ψυχολογικά οφέλη: Η γνώση της νόσου σε αρχικό στάδιο μπορεί να προσφέρει στους ασθενείς και τις οικογένειές τους περισσότερο χρόνο για να προετοιμαστούν, να ενημερωθούν και να λάβουν αποφάσεις σχετικά με τη θεραπεία.
Αυτή η έρευνα αποτελεί ένα σημαντικό βήμα προς την ανάπτυξη προσβάσιμων και αποτελεσματικών διαγνωστικών εργαλείων που θα μπορούσαν να χρησιμοποιηθούν ακόμα και σε γενικούς πληθυσμούς. Φανταστείτε ένα μέλλον όπου μια απλή εξέταση αίματος θα μπορούσε να ανιχνεύει τον καρκίνο χρόνια πριν εμφανιστούν συμπτώματα, επιτρέποντας την άμεση παρέμβαση και σώζοντας αναρίθμητες ζωές.
Ενώ απαιτούνται περαιτέρω μελέτες και κλινικές δοκιμές για την ευρεία εφαρμογή αυτής της τεχνολογίας, η προοπτική είναι άκρως ενθαρρυντική. Η επιστήμη συνεχίζει να μας εκπλήσσει με τις δυνατότητές της να μεταμορφώνει την ιατρική και να προσφέρει ελπίδα σε εκατομμύρια ανθρώπους.